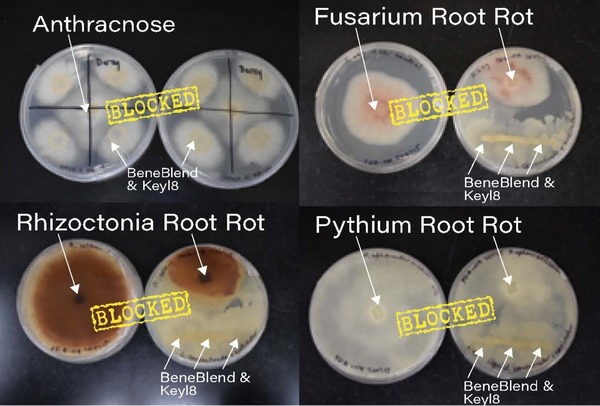

Maximize Crop Yields and Sustainability with Seed Biopriming and Humic Acids
SOIL BIOLOGYPLANT HEALTH

Discover the revolutionary technique of seed biopriming and how it enhances crop yield and sustainability in our latest blog article. Learn about the integration of beneficial microorganisms with seed hydration, which improves germination, stress tolerance, and nutrient uptake. Explore research on the role of endophytic bacteria in promoting seedling growth and root development. Uncover the benefits of using BeneBlend SS, a superior plant probiotic, to fortify microbial populations and support sustainable farming practices.
Enhancing Crop Yield and Sustainability through Seed Biopriming with Humic Acids, Biologicals, and Compost Extracts
In the pursuit of sustainable agricultural practices, seed biopriming has emerged as a groundbreaking technique offering numerous benefits to farmers and the environment. This method involves hydrating seeds and treating them with beneficial microorganisms (biologicals), sometimes in combination with natural substances like humic acids and compost extracts. The integration of humic acids, biologicals, and compost extracts in seed treatments not only enhances seed germination but also improves plant growth, increases resilience to stress, and boosts overall crop yield.
The Role of Humic Acids in Seed Biopriming
Humic acids are complex organic molecules resulting from the decomposition of plant and animal matter. They are a key component of humus, the organic portion of soil, and are known for their ability to improve soil fertility and plant health. When used in seed treatments, humic acids offer several potential benefits:
Enhanced Nutrient Uptake
Chelation of Nutrients: Humic acids can bind to essential micronutrients like iron, zinc, and manganese, making them more readily available for plant absorption.
Improved Root Membrane Permeability: They enhance the permeability of root cell membranes, facilitating more efficient nutrient and water uptake.
Stimulated Root Development
Root Growth Promotion: Humic acids stimulate root elongation and branching, leading to a more extensive root system.
Increased Root Hairs: They promote the formation of root hairs, increasing the root surface area for absorption.
Improved Seed Germination and Seedling Vigor
Activation of Enzymes: Humic acids activate enzymes involved in germination, leading to faster and more uniform sprouting.
Enhanced Energy Availability: They improve the energy status of seeds by influencing respiration and metabolic activities.
Increased Stress Tolerance
Abiotic Stress Mitigation: Humic acids help plants cope with stresses like drought, salinity, and extreme temperatures by improving water retention and antioxidant activity.
Hormonal Balance: They influence the balance of plant hormones such as auxins and gibberellins, which regulate stress responses.
Promotion of Beneficial Microbial Activity
Microbial Food Source: Humic acids serve as a carbon source for beneficial soil microbes, stimulating their growth and activity.
Synergistic Effects: They enhance the effectiveness of biological inoculants by providing a supportive environment.
Benefits of Pairing Humic Acids with Biologicals and Compost Extracts in Seed Treatment
Combining humic acids, beneficial microorganisms, and compost extracts in seed treatments creates a synergistic effect that amplifies the benefits of each component. This partnership leads to several potential advantages:
Enhanced Microbial Viability and Efficacy
Protective Environment: Humic acids and compost extracts can shield microorganisms from environmental stresses during and after application.
Increased Colonization: They promote the establishment and proliferation of beneficial microbes on seed surfaces and in the rhizosphere.
Synergistic Plant Growth Promotion
Accelerated Growth: The combination leads to enhanced production of plant growth-promoting substances like indole-3-acetic acid (IAA) and gibberellins.
Nutrient Solubilization: Biologicals like phosphate-solubilizing bacteria work more effectively in the presence of humic acids and compost extracts, increasing the availability of phosphorus and other nutrients.
Improved Stress Resistance
Enhanced Defense Mechanisms: The combination boosts the plant's immune responses, helping to fend off pathogens and pests.
Osmotic Balance: They assist in maintaining cellular osmotic balance under stress conditions, improving plant survival rates.
Soil Health and Fertility
Soil Structure Improvement: Humic acids and compost extracts aid in the formation of soil aggregates, enhancing aeration and water infiltration.
Microbial Diversity: The presence of humic substances and compost extracts encourages a diverse microbial community, which contributes to nutrient cycling and soil fertility.
The Role of Compost and Worm Casting Extracts
Compost and worm casting extracts are nutrient-rich solutions derived from the leachate of composted organic materials and vermicompost. These extracts contain a wide variety of beneficial microorganisms, humic substances, and plant growth-promoting compounds that can significantly enhance seed biopriming.
Benefits of Compost and Worm Casting Extracts
Microbial Diversity: Compost and worm casting extracts introduce a diverse range of beneficial microorganisms, including bacteria, fungi, and protozoa, which can help suppress pathogens and enhance soil health.
Enhanced Nutrient Availability: These extracts are rich in soluble nutrients and microbial metabolites that promote nutrient uptake by seeds and seedlings. They help mobilize phosphorus, potassium, and trace elements, making them readily available to plants.
Improved Seedling Vigor and Growth: The presence of plant growth hormones like auxins and cytokinins in worm casting extracts promotes better root and shoot development. This leads to more vigorous seedlings with improved resilience to environmental stressors.
Disease Suppression: Compost extracts contain microorganisms that produce natural antibiotics and compete with harmful pathogens, providing biological control against seed-borne and soil-borne diseases.
Enhanced Soil Fertility: Worm casting extracts improve soil fertility by increasing microbial activity and organic matter content, leading to healthier soil that supports long-term crop productivity.
Practical Applications and Considerations
Selecting Appropriate Biologicals
Choosing the right strains of beneficial microorganisms to pair with broad-spectrum extracts can maximize the benefits:
Nitrogen-Fixing Bacteria: Such as Rhizobium and Azotobacter, which convert atmospheric nitrogen into forms usable by plants.
Phosphate-Solubilizing Bacteria: Like Pseudomonas species, which make phosphorus more available.
Mycorrhizal Fungi: Form symbiotic relationships with plant roots, enhancing water and nutrient uptake.
Compost and Worm Extracts: These can be used to introduce a wide range of beneficial microorganisms and plant growth-promoting substances.
Application Methods
Seed Coating: Applying a layer containing humic acids, biologicals, and compost extracts directly onto the seed surface.
Seed Soaking (Priming): Immersing seeds in a solution of humic acids, compost extracts, and microbial inoculants for a specified period before planting.
Pelleting: Enclosing seeds within a pellet that contains humic substances, compost extracts, and beneficial microbes, protecting them until germination.
Ensuring Compatibility and Effectiveness
Formulation Stability: It's important to ensure that humic acids, compost extracts, and biologicals remain stable and viable during storage and application.
Optimal Conditions: Factors like pH, temperature, and moisture levels should be optimized to maintain microbial activity.
Quality Control: Using high-quality humic substances, compost extracts, and verified microbial strains enhances the effectiveness of the treatment.
Case Studies and Research Highlights
Enhanced Germination and Growth
Studies have shown that seeds treated with humic acids, biologicals, and compost extracts exhibit:
Higher Germination Rates: Due to improved enzyme activity and energy metabolism.
Increased Seedling Vigor: Resulting from better nutrient uptake, hormonal stimulation, and microbial interactions.
Stress Tolerance Improvements
Research indicates that such treatments can lead to:
Better Drought Resistance: Through enhanced root systems, osmoprotectant accumulation, and microbial activity.
Salinity Stress Mitigation: By regulating ion uptake, improving antioxidant defenses, and enhancing soil microbial communities.
Yield and Quality Enhancement
Field trials have demonstrated:
Higher Crop Yields: Attributed to improved plant health, resource use efficiency, and microbial support.
Improved Crop Quality: Including better nutrient content, taste, and shelf life.
Environmental and Economic Benefits
Reduced Reliance on Chemical Inputs
Lower Fertilizer Use: Enhanced nutrient uptake efficiency means less dependence on synthetic fertilizers.
Decreased Pesticide Need: Improved plant defenses and disease suppression reduce the necessity for chemical pesticides.
Sustainability and Soil Health
Soil Conservation: Healthier soils with better structure and microbial activity contribute to long-term agricultural sustainability.
Environmental Protection: Reduced chemical runoff minimizes pollution of water bodies and preserves ecosystems.
Cost-Effectiveness
Economic Savings: Lower input costs and higher yields can improve profit margins for farmers.
Resource Efficiency: More efficient use of water and nutrients conserves valuable resources.
The integration of humic acids, biologicals, and compost extracts in seed biopriming represents a significant advancement in sustainable agriculture. This approach leverages natural processes to enhance plant growth, improve stress tolerance, and increase crop yields while promoting environmental stewardship.
Key Takeaways:
Synergistic Benefits: The combination amplifies the positive effects on seed germination, plant growth, and stress resistance.
Sustainable Practice: It aligns with global efforts to reduce chemical inputs and adopt eco-friendly farming methods.
Economic Advantage: Farmers can achieve higher productivity and profitability with potentially lower input costs.
Future Outlook:
As agricultural challenges like climate change and soil degradation intensify, practices like seed biopriming with humic acids, biologicals, and compost extracts will become increasingly important. Ongoing research and technological advancements will likely enhance the effectiveness and accessibility of these treatments, making them a cornerstone of sustainable agriculture.
Recommendations for Farmers:
Trial Implementation: Start with small-scale trials to observe the benefits under specific field conditions.
Consultation with Experts: Work with agronomists or soil scientists with experience to select appropriate humic products, compost extracts, and microbial strains.
Monitoring and Adjustment: Regularly monitor crop performance and adjust practices as needed to optimize results.
By embracing these innovative seed treatment strategies, farmers can contribute to a more sustainable food system while reaping the benefits of healthier crops and improved yields.


